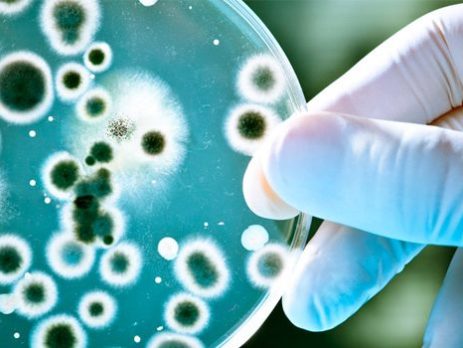

DE LA UNIVERSIDAD AL MUNDO LABORAL
Profesor de Biología y Ciencias naturales Jefe del Departamento de Ciencias del Colegio Inglés Católico de La Serena Titulado año 2013 ¿Cuál es el mejor recuerdo de su paso por la ULS? Hay varias situaciones para el recuerdo, pero sin duda lo mejor era el tiempo que pasábamos con mis amig@s colegas antes [...]